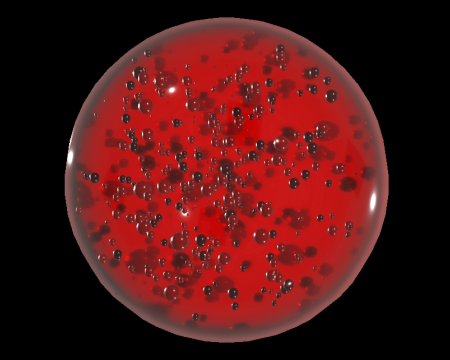
Image of Animus Orb

Cleanroom - ARK B2
Standard (Modern)Inside the black and red case on the north side of the room.
A beautiful crimson orb. One of the objects needed to enter the administration area within ARK.
| Category | Item (Key item) |
|---|



There are no locations to show for this game mode. The following game modes are applicable:
